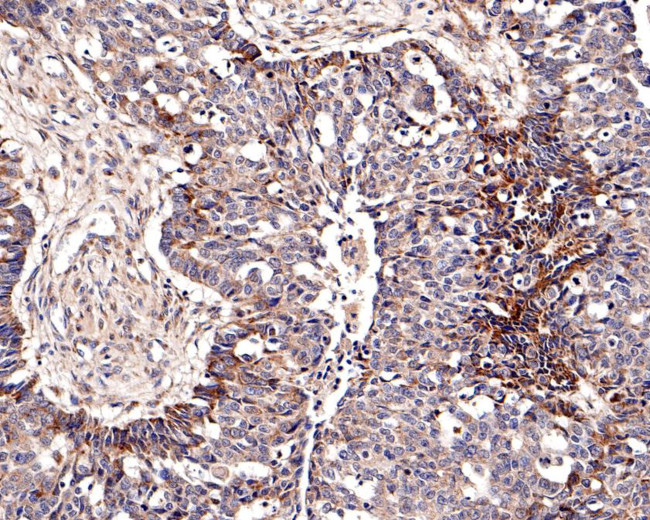
ChT1 Antibody in Immunohistochemistry (Paraffin) (IHC (P))

Search
Huabio
ChT1 Polyclonal Antibody
{{$productOrderCtrl.translations['antibody.pdp.commerceCard.promotion.promotions']}}
{{$productOrderCtrl.translations['antibody.pdp.commerceCard.promotion.viewpromo']}}
{{$productOrderCtrl.translations['antibody.pdp.commerceCard.promotion.promocode']}}: {{promo.promoCode}} {{promo.promoTitle}} {{promo.promoDescription}}. {{$productOrderCtrl.translations['antibody.pdp.commerceCard.promotion.learnmore']}}
图: 1 / 3
ChT1 Antibody (HA500237) in IHC (P)



产品信息
HA500237
种属反应
宿主/亚型
分类
类型
抗原
偶联物
形式
浓度
规格
纯化类型
保存液
内含物
保存条件
运输条件
靶标信息
VSIG1 encodes a member of the junctional adhesion molecule (JAM) family. The encoded protein contains multiple glycosylation sites at the N-terminal region, and multiple phosphorylation sites and glutamic acid/proline (EP) repeats at the C-terminal region. The gene is expressed in normal stomach and testis, as well as in gastric, esophageal and ovarian cancers. Alternatively spliced transcript variants encoding different isoforms have been found for this gene.
仅用于科研。不用于诊断过程。未经明确授权不得转售。
篇参考文献 (0)
生物信息学
蛋白别名: Cell surface A33 antigen; Glycoprotein A34; MGC44287; unnamed protein product; V-set and immunoglobulin domain-containing protein 1
基因别名: 1700062D20Rik; 4930405J24Rik; dJ889N15.1; GPA34; VSIG1
UniProt ID: (Human) Q86XK7, (Mouse) Q9D2J4, (Rat) Q4KLY3
Entrez Gene ID: (Human) 340547, (Mouse) 78789, (Rat) 315920